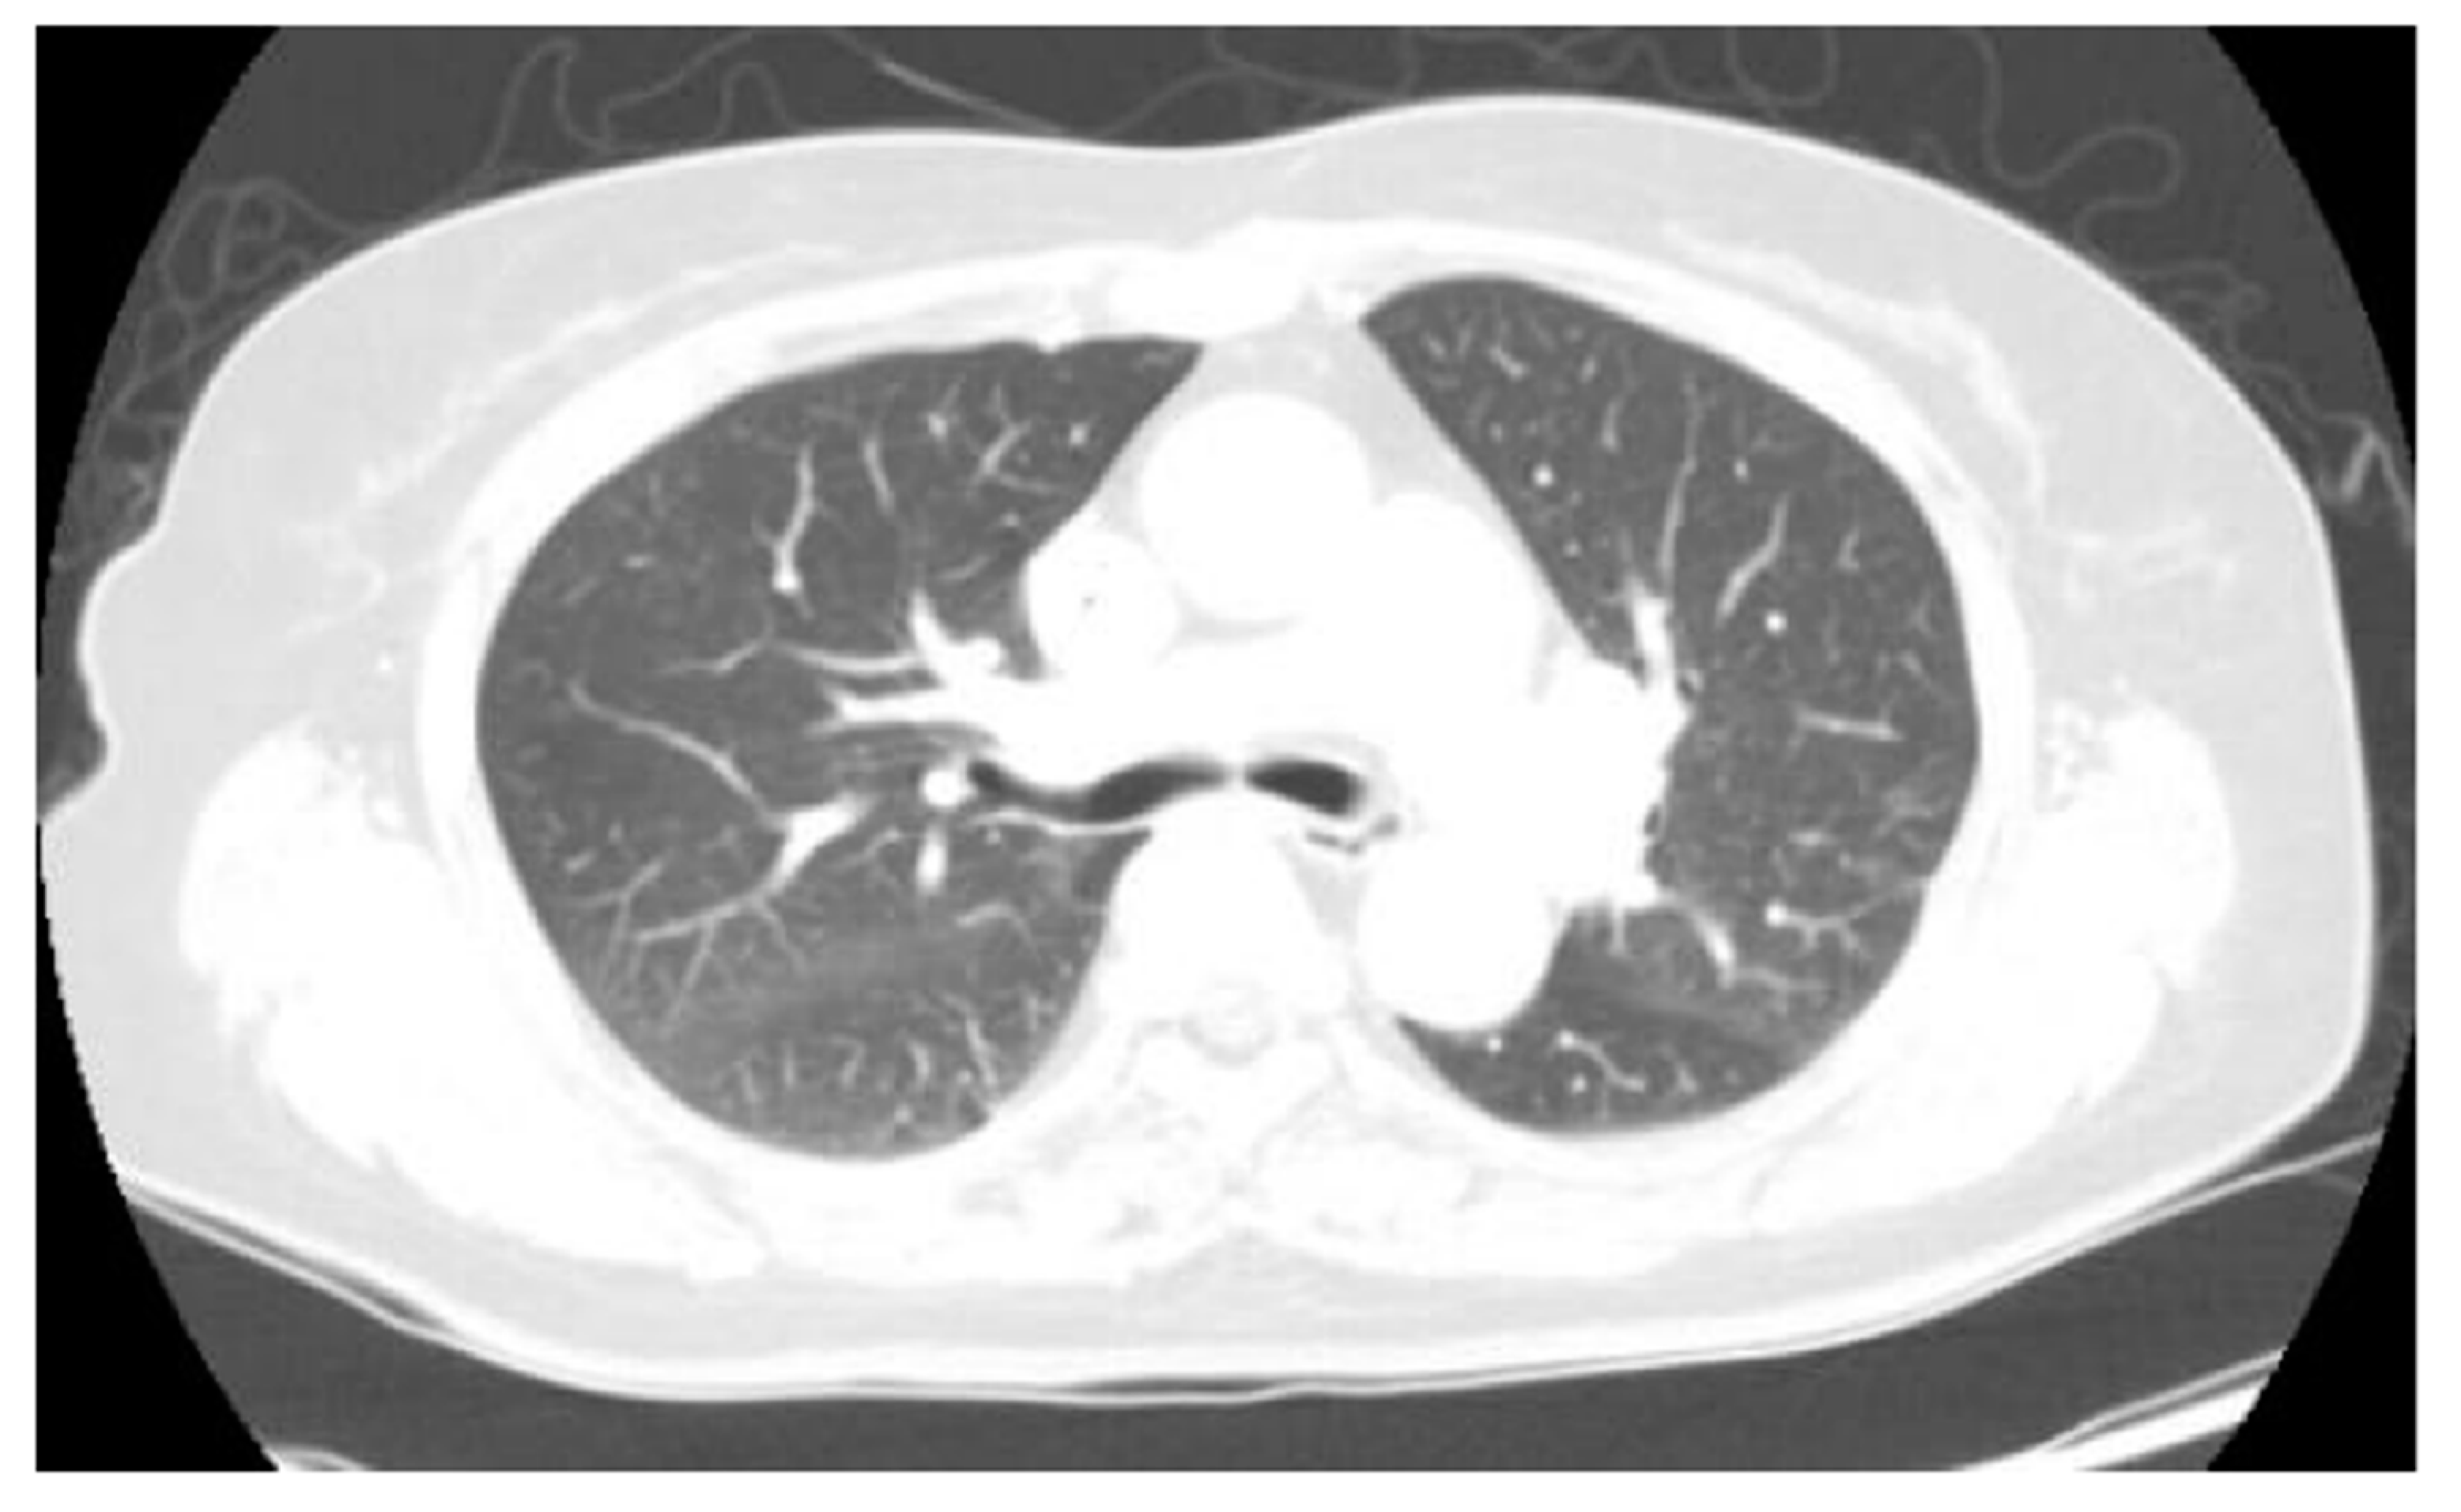
Diagnostics 12 02479 g003 Diagnostics 12 02479 g003

Septic Pulmonary Emboli Detected by 18F-FDG PET/CT in a Patient with Central Venous Catheter-Related Staphylococcus aureus Bacteremia
Abstract

Author Contributions
Funding
Institutional Review Board Statement
Informed Consent Statement
Data Availability Statement
Conflicts of Interest
References
- Hustinx, R.; Bénard, F.; Alavi, A. Whole-body FDG-PET imaging in the management of patients with cancer. Semin. Nucl. Med. 2002, 32, 35–46. [Google Scholar] [CrossRef] [PubMed]
- Bar-Shalom, R.; Valdivia, A.Y.; Blaufox, M.D. PET imaging in oncology. Semin. Nucl. Med. 2000, 30, 150–185. [Google Scholar] [CrossRef]
- Yamada, S.; Kubota, K.; Kubota, R.; Ido, T.; Tamahashi, N. High accumulation of fluorine-18-fluorodeoxyglucose in turpentine-induced inflammatory tissue. J. Nucl. Med. 1995, 36, 1301–1306. [Google Scholar]
- Mermel, L.A.; Allon, M.; Bouza, E.; Craven, D.E.; Flynn, P.; O’Grady, N.P.; Raad, I.I.; Rijnders, B.J.A.; Sherertz, R.J.; Warren, D.K. Clinical Practice Guidelines for the Diagnosis and Management of Intravascular Catheter-Related Infection: 2009 Update by the Infectious Diseases Society of America. Clin. Infect. Dis. 2009, 49, 1–45. [Google Scholar] [CrossRef]
- Vos, F.J.; Bleeker-Rovers, C.P.; Sturm, P.D.; Krabbe, P.F.; van Dijk, A.P.; Cuijpers, M.L.; Adang, E.M.; Wanten, G.J.; Kullberg, B.-J.; Oyen, W.J. 18F-FDG PET/CT for Detection of Metastatic Infection in Gram-Positive Bacteremia. J. Nucl. Med. 2010, 51, 1234–1240. [Google Scholar] [CrossRef]
- Vos, F.J.; Kullberg, B.J.; Sturm, P.D.; Krabbe, P.F.M.; van Dijk, A.P.J.; Wanten, G.J.A.; Oyen, W.J.G.; Bleeker-Rovers, C.P. Metastatic Infectious Disease and Clinical Outcome in Staphylococcus aureus and Streptococcus species Bacteremia. Medicine 2012, 91, 86–94. [Google Scholar] [CrossRef] [PubMed]
- Kaasch, A.J.; Barlow, G.; Edgeworth, J.D.; Fowler, V.G., Jr.; Hellmich, M.; Hopkins, S.; Kern, W.V.; Llewelyn, M.J.; Rieg, S.; Rodriguez-Baño, J.; et al. Staphylococcus aureus bloodstream infection: A pooled analysis of five prospective, observational studies. J. Infect. 2014, 68, 242–251. [Google Scholar] [CrossRef] [PubMed]
- El Zakhem, A.; Chaftari, A.M.; Bahu, R.; El Helou, G.; Shelburne, S.; Jiang, Y.; Hachem, R.; Raad, I. Central line-associated bloodstream infections caused by Staphylococcus aureus in cancer patients: Clinical outcome and management. Ann. Med. 2014, 43, 163–168. [Google Scholar] [CrossRef] [PubMed]
- Park, K.-H.; Lee, Y.-M.; Hong, H.-L.; Kim, T.; Park, H.J.; Park, S.-Y.; Moon, S.M.; Chong, Y.P.; Kim, S.-H.; Lee, S.-O.; et al. Persistent Catheter-Related Staphylococcus aureus Bacteremia after Catheter Removal and Initiation of Antimicrobial Therapy. PLoS ONE 2012, 7, e46389. [Google Scholar] [CrossRef]
- Ghanem-Zoubi, N.; Kagna, O.; Abu-Elhija, J.; Mustafa-Hellou, M.; Qasum, M.; Keidar, Z.; Paul, M. Integration of FDG-PET/CT in the Diagnostic Workup for Staphylococcus aureus Bacteremia: A Prospective Interventional Matched-cohort Study. Clin. Infect. Dis. 2020, 73, e3859–e3866. [Google Scholar] [CrossRef] [PubMed]
- Berrevoets, M.A.; Kouijzer, I.J.; Aarntzen, E.H.; Janssen, M.J.; De Geus-Oei, L.-F.; Wertheim, H.F.; Kullberg, B.-J.; Oever, J.T.; Oyen, W.J.G.; Bleeker-Rovers, C.P. 18F-FDG PET/CT Optimizes Treatment in Staphylococcus aureus Bacteremia and Is Associated with Reduced Mortality. J. Nucl. Med. 2017, 58, 1504–1510. [Google Scholar] [CrossRef] [PubMed]
- Berrevoets, M.A.H.; Kouijzer, I.J.E.; Slieker, K.; Aarntzen, E.; Kullberg, B.K.; Oever, J.T.; Bleeker-Rovers, C.P. (18)F-FDG PET/CT-guided treatment du-ration in patients with high-risk Staphylococcus aureus bacteremia: A proof of principle. J. Nucl. Med. 2019, 60, 998–1002. [Google Scholar] [CrossRef] [PubMed]
- Rosenbaum, S.J.; Lind, T.; Antoch, G.; Bockisch, A. False-Positive FDG PET Uptake−the Role of PET/CT. Eur. Radiol. 2005, 16, 1054–1065. [Google Scholar] [CrossRef]
- Love, C.; Tomas, M.B.; Tronco, G.G.; Palestro, C.J. FDG PET of Infection and Inflammation. RadioGraphics 2005, 25, 1357–1368. [Google Scholar] [CrossRef] [PubMed]
- Mochizuki, T.; Tsukamoto, E.; Kuge, Y.; Kanegae, K.; Zhao, S.; Hikosaka, K.; Hosokawa, M.; Kohanawa, M.; Tamaki, N. FDG uptake and glucose transporter subtype expressions in experimental tumor and inflammation models. J. Nucl. Med. 2001, 42, 1551–1555. [Google Scholar]
- Chang, J.M.; Lee, H.J.; Goo, J.M.; Lee, H.-Y.; Lee, J.J.; Chung, J.-K.; Im, J.-G. False Positive and False Negative FDG-PET Scans in Various Thoracic Diseases. Korean J. Radiol. 2006, 7, 57–69. [Google Scholar] [CrossRef]
- Jorens, P.G.; Van Marck, E.; Snoeckx, A.; Parizel, P.M. Nonthrombotic pulmonary embolism. Eur. Respir. J. 2009, 34, 452–474. [Google Scholar] [CrossRef]
- Gompelman, M.; Tuinte, R.; Aarntzen, E.; Kouijzer, I.; van Leerdam, E.; Berrevoets, M.; Oever, J.T.; Bleeker-Rovers, C.; Wanten, G. The diagnostic value of [18F]FDG-PET/CT in detecting septic thrombosis in patients with central venous catheter-related Staphylococcus aureus bacteremia. Biomed. Pharmacother. 2021, 144, 112296. [Google Scholar] [CrossRef]
- Bhargava, P.; Kumar, R.; Zhuang, H.; Charron, M.; Alavi, A. Catheter-ralted focal FDG activity on whole body PET imaging. Clin. Nucl. Med. 2004, 29, 238–242. [Google Scholar] [CrossRef]
- Bleeker-Rovers, C.P.; Vos, F.J.; Wanten, G.J.; van der Meer, J.W.; Corstens, F.H.; Kullberg, B.J.; Oyen, W.J. 18F-FDG PET in detecting metastatic infectious disease. J. Nucl. Med. 2005, 46, 2014–2019. [Google Scholar]
Publisher’s Note: MDPI stays neutral with regard to jurisdictional claims in published maps and institutional affiliations. |
© 2022 by the authors. Licensee MDPI, Basel, Switzerland. This article is an open access article distributed under the terms and conditions of the Creative Commons Attribution (CC BY) license (https://creativecommons.org/licenses/by/4.0/).
Share and Cite
Yoo, J.; Cheon, M. Septic Pulmonary Emboli Detected by 18F-FDG PET/CT in a Patient with Central Venous Catheter-Related Staphylococcus aureus Bacteremia. Diagnostics 2022, 12, 2479. https://doi.org/10.3390/diagnostics12102479
Yoo J, Cheon M. Septic Pulmonary Emboli Detected by 18F-FDG PET/CT in a Patient with Central Venous Catheter-Related Staphylococcus aureus Bacteremia. Diagnostics. 2022; 12(10):2479. https://doi.org/10.3390/diagnostics12102479
Chicago/Turabian StyleYoo, Jang, and Miju Cheon. 2022. "Septic Pulmonary Emboli Detected by 18F-FDG PET/CT in a Patient with Central Venous Catheter-Related Staphylococcus aureus Bacteremia" Diagnostics 12, no. 10: 2479. https://doi.org/10.3390/diagnostics12102479
APA StyleYoo, J., & Cheon, M. (2022). Septic Pulmonary Emboli Detected by 18F-FDG PET/CT in a Patient with Central Venous Catheter-Related Staphylococcus aureus Bacteremia. Diagnostics, 12(10), 2479. https://doi.org/10.3390/diagnostics12102479

